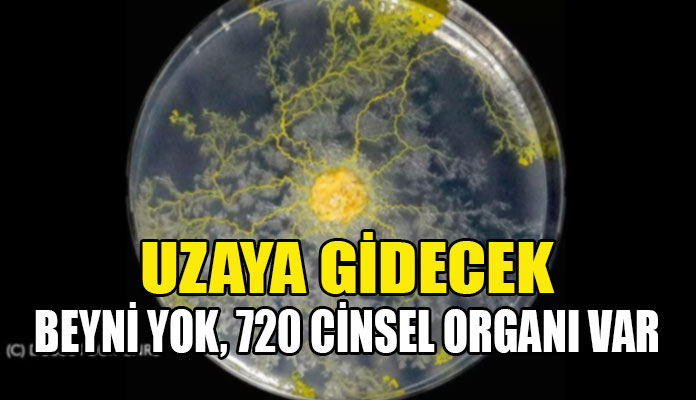

Fransız Ulusal Uzay Araştırmaları Merkezi (CNES) ile Fransız Ulusal Bilimsel Araştırma Merkezi (CNRS)’nin beraber yürüttüğü proje kapsamında, Uluslararası Uzay İstasyonu’ndaki astronotlar sıra dışı bir konuk ağırlamaya hazırlanıyor.
Projenin amacı, tek hücreli canlı mantar gibi görünen ama bir hayvan gibi hareket eden ve tam 720 cinsel organa sahip olan Blob’u yerçekimsiz ortamda gözlemlemek.
Deney, Dünya’da ve uzayda eş zamanlı gerçekleştirilecek
CNES’den yer bilimleri ve yaşam profesörü Pierre Ferrand’ın öncülüğünde gerçekleşecek deney, eş zamanlı olarak Dünya’da da gerçekleştirilecek. Bilim insanları hala sınıflandıramadıkları bu organizmanın uzaydaki hareketlerini gözlemlerken, yüz binlerce Fransız öğrenci de deneyin bir parçası olacak. Uzaya gönderilen Blob’dan alınan örnekler, Fransa’daki 4 bin 500 okula dağıtılacak. Böylece yerçekimsiz ortamdaki Blob ile Dünya’dakinin hareketleri karşılaştırılabilecek.
İkiye bölünse bile kendisini iki dakika içinde tamamlayabilen ve bacakları olmadığı halde saatte 4 cm mesafe kat edebilen Blob’un uzayda bu işlevlerini nasıl kullanacağı merak konusu. Bilim insanları, deneyin yaşamın temel yapı taşlarına ilişkin bazı sorulara ışık tutabileceğini düşünüyor.
Profesör Ferrand, “Bugün kimse Blob’un mikro yerçekiminde nasıl bir davranış sergileyeceğini bilmiyor. Hangi yönde hareket edecek: yukarıya doğru mu yoksa yatay bir şekilde mi? Örneğin, hücre teorisine göre, her hücrenin iki hücreye bölündüğünü söylüyoruz. Blob ise kendini hiç bölmeden büyüyebilen tek bir canlı olduğu için işler bu şekilde ilerlemiyor” ifadelerini kullandı.
Ne bitki ne hayvan ne de mantar
Myxomycetes familyasının bir üyesi olan Blob, cıvık mantarlar kategorisinde görülüyor. Ancak bu haliyle ne bir bitki ne mantar ne de bir hayvan olarak sınıflandırılıyor. Biyologlar henüz karar vermedi.
Bu türe adını veren ise 1958 yapımı bir bilimkurgu filmi olan ‘The Blob’ oldu. ‘Büyüyen Canavar’ adıyla bilinen ve Steve McQueen’in başrolünde olduğu filmde, uzaydan gelen bir yaşam formunun Pennsylvania’da küçük bir kasabada giderek her şeyi tüketir hale gelmesi konu ediliyordu.
Blob daha önce 2019’da Fransa’da bir hayvanat bahçesinde sergilenmişti.
































